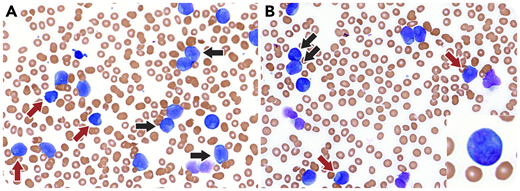
A 58-year-old man presented with a white blood cell count of 126 × 103/μL, hemoglobin of 10.7 g/dL, a platelet count of 45 × 103/μL, and a D-dimer of 12.01 μg/nL fractional excretion of urea. A peripheral smear revealed 97% blasts, demonstrating prominently cleaved nuclei with fine chromatin, prominent nucleoli, Auer rods, and occasional cup-like nuclei (panels A-B: black arrows, cleaved nuclei; red arrows, cup-like nuclei; Wright-Giemsa stain; original magnification ×400; inset, blast with Auer rod, original magnification ×400). Flow cytometry revealed abnormal myeloid blasts expressing myeloperoxidase, CD13, CD33, CD117, CD38, CD64, CD4, and lacking CD34, CD11B, and HLA-DR. Cytogenetics showed a normal 46,XY karyotype, and there was no evidence of promyelocytic leukemia/retinoic acid receptor α (PML-RARA) by fluorescence in situ hybridization (FISH) or real-time polymerase chain reaction. Next-generation sequencing revealed pathogenic variants in nucleophosmin 1 (NPM1; c.860_863dup), DNA methyltransferase 3A (DNMT3A; c.1054delA), isocitrate dehydrogenase 2 (IDH2; c.419G>A), and an FLT3 internal tandem duplication (ITD).

A 58-year-old man presented with a white blood cell count of 126 × 103/μL, hemoglobin of 10.7 g/dL, a platelet count of 45 × 103/μL, and a D-dimer of 12.01 μg/nL fractional excretion of urea. A peripheral smear revealed 97% blasts, demonstrating prominently cleaved nuclei with fine chromatin, prominent nucleoli, Auer rods, and occasional cup-like nuclei (panels A-B: black arrows, cleaved nuclei; red arrows, cup-like nuclei; Wright-Giemsa stain; original magnification ×400; inset, blast with Auer rod, original magnification ×400). Flow cytometry revealed abnormal myeloid blasts expressing myeloperoxidase, CD13, CD33, CD117, CD38, CD64, CD4, and lacking CD34, CD11B, and HLA-DR. Cytogenetics showed a normal 46,XY karyotype, and there was no evidence of promyelocytic leukemia/retinoic acid receptor α (PML-RARA) by fluorescence in situ hybridization (FISH) or real-time polymerase chain reaction. Next-generation sequencing revealed pathogenic variants in nucleophosmin 1 (NPM1; c.860_863dup), DNA methyltransferase 3A (DNMT3A; c.1054delA), isocitrate dehydrogenase 2 (IDH2; c.419G>A), and an FLT3 internal tandem duplication (ITD).
Although the cleaved nuclei and lack of CD34 and HLA-DR are suggestive of acute promyelocytic leukemia (APL) with hypogranular morphology, acute myeloid leukemia (AML) with mutated NPM1 and/or FLT3 ITD often shows loss of CD34 and HLA-DR and presents with a high D-dimer. In some cases, such as this one, the nuclear features mimic APL, although some blasts show the distinctive cup-like nuclei of AML with mutated NPM1 and/or FLT3 ITD. Therefore, it is important to consider AML with NPM1 and/or FLT3 ITD in cases that have features suggestive of APL but are negative for PML-RARA by FISH and/or molecular methods.
A 58-year-old man presented with a white blood cell count of 126 × 103/μL, hemoglobin of 10.7 g/dL, a platelet count of 45 × 103/μL, and a D-dimer of 12.01 μg/nL fractional excretion of urea. A peripheral smear revealed 97% blasts, demonstrating prominently cleaved nuclei with fine chromatin, prominent nucleoli, Auer rods, and occasional cup-like nuclei (panels A-B: black arrows, cleaved nuclei; red arrows, cup-like nuclei; Wright-Giemsa stain; original magnification ×400; inset, blast with Auer rod, original magnification ×400). Flow cytometry revealed abnormal myeloid blasts expressing myeloperoxidase, CD13, CD33, CD117, CD38, CD64, CD4, and lacking CD34, CD11B, and HLA-DR. Cytogenetics showed a normal 46,XY karyotype, and there was no evidence of promyelocytic leukemia/retinoic acid receptor α (PML-RARA) by fluorescence in situ hybridization (FISH) or real-time polymerase chain reaction. Next-generation sequencing revealed pathogenic variants in nucleophosmin 1 (NPM1; c.860_863dup), DNA methyltransferase 3A (DNMT3A; c.1054delA), isocitrate dehydrogenase 2 (IDH2; c.419G>A), and an FLT3 internal tandem duplication (ITD).
Although the cleaved nuclei and lack of CD34 and HLA-DR are suggestive of acute promyelocytic leukemia (APL) with hypogranular morphology, acute myeloid leukemia (AML) with mutated NPM1 and/or FLT3 ITD often shows loss of CD34 and HLA-DR and presents with a high D-dimer. In some cases, such as this one, the nuclear features mimic APL, although some blasts show the distinctive cup-like nuclei of AML with mutated NPM1 and/or FLT3 ITD. Therefore, it is important to consider AML with NPM1 and/or FLT3 ITD in cases that have features suggestive of APL but are negative for PML-RARA by FISH and/or molecular methods.
For additional images, visit the ASH Image Bank, a reference and teaching tool that is continually updated with new atlas and case study images. For more information, visit http://imagebank.hematology.org.

This feature is available to Subscribers Only
Sign In or Create an Account Close Modal